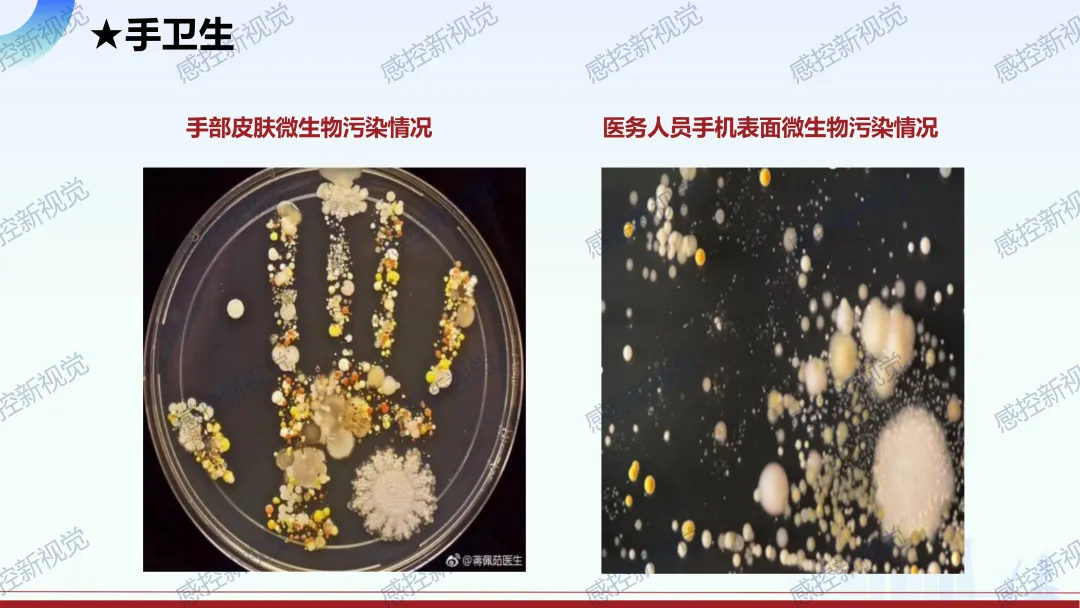

【PPT】如何提升医务人员手卫生依从性
- 2026-04-04 11:07:09
【PPT】如何提升医务人员手卫生依从性





















需要可编辑的电子版资料,请识别二维码或加小编微信:haohu20080410咨询 
- 推荐文章, 点击阅读 - 【 精选PPT 】 建议收藏!2025年感控新视觉公众号PPT整理链接汇总! 建议收藏!14项感控行业新标准2026年2月1日起实施(合集链接汇总) 建议收藏!2026年(1-2月份)感控新视觉PPT汇总! 【PPT】十四项院感新标准整合解读与工作落实要点 【PPT】创伤救护技能知识培训 【PPT】围手术期感染预防与控制 【PPT】发热伴血小板减少综合征临床诊治与院感防控 【PPT】医疗机构抗菌药物合理应用管理工作实施方案 【PPT】艰难梭菌院感暴发桌面演练方案 【PPT】手术部(室)医院感染控制标准解读 【PPT】国家传染病智能监测预警前置软件应用实践 【PPT】医院感染风险评估指南 【PPT】心肺复苏与胸外心脏电除颤操作培训 【PPT】医疗机构常用消毒方法 【PPT】医院消毒灭菌效果监测 【PPT】发热伴血小板减少综合征防控方案(2026版) 【 精选word文档 】 建议收藏!2025年感控新视觉公众号word文档整理链接汇总! 医院感染预防与控制标准操作规程(SOP)2026年2月最新修订 医疗机构疾控和公共卫生科管理制度汇编(2026版) 医疗废物管理制度(2026年版) 医院感染管理知识竞赛试题库 医疗机构保洁人员工作手册 医院感染风险管理实施方案 重点环节、重点人群与高危险因素管理与监测计划 2026年医院多重耐药菌感染防控措施实施方案 医院手卫生依从性监测方案 常见传染病防控知识要点 重点传染病诊断标准及防治要点 《北京市医疗机构重点传染病早期识别指南》 《北京市护士长管理手册》模板 建立医院侵入性操作目录、制度、过程监测与督导实践建议(附:侵入性操作名录) 静脉血标本采集质量评价标准 












// 免责声明 1.本公众号部分转载的文章、图文、视频来自网络,其版权和文责属原作者所有,若来源标注错误或侵犯到您的权益,烦请告知,我们将立即删除。 2.本公众号目的在于分享有关健康的最新内容。信息只供参考,不代表赞同或保证信息的准确性、有效性、及时性和完整性,也不构成任何其他建议,如有疏漏,请多批评指正,也请多提修改意见和建议。不承担因该些内容已过时、所引用资料可能的不准确或不完整等情况引起的任何责任。 3.本公众号编辑部工作人员的原创文章,其版权属于我们微信公众号所属主体。若要转载原创文章用于商业用途,请联系我们,未经同意不得转载。任何转载请注明文章来源。如有问题,请联系我们,谢谢!微信:haohu20080410

全文37页,仅展示部分内容......


往期精选













本文来自网友投稿或网络内容,如有侵犯您的权益请联系我们删除,联系邮箱:wyl860211@qq.com 。
